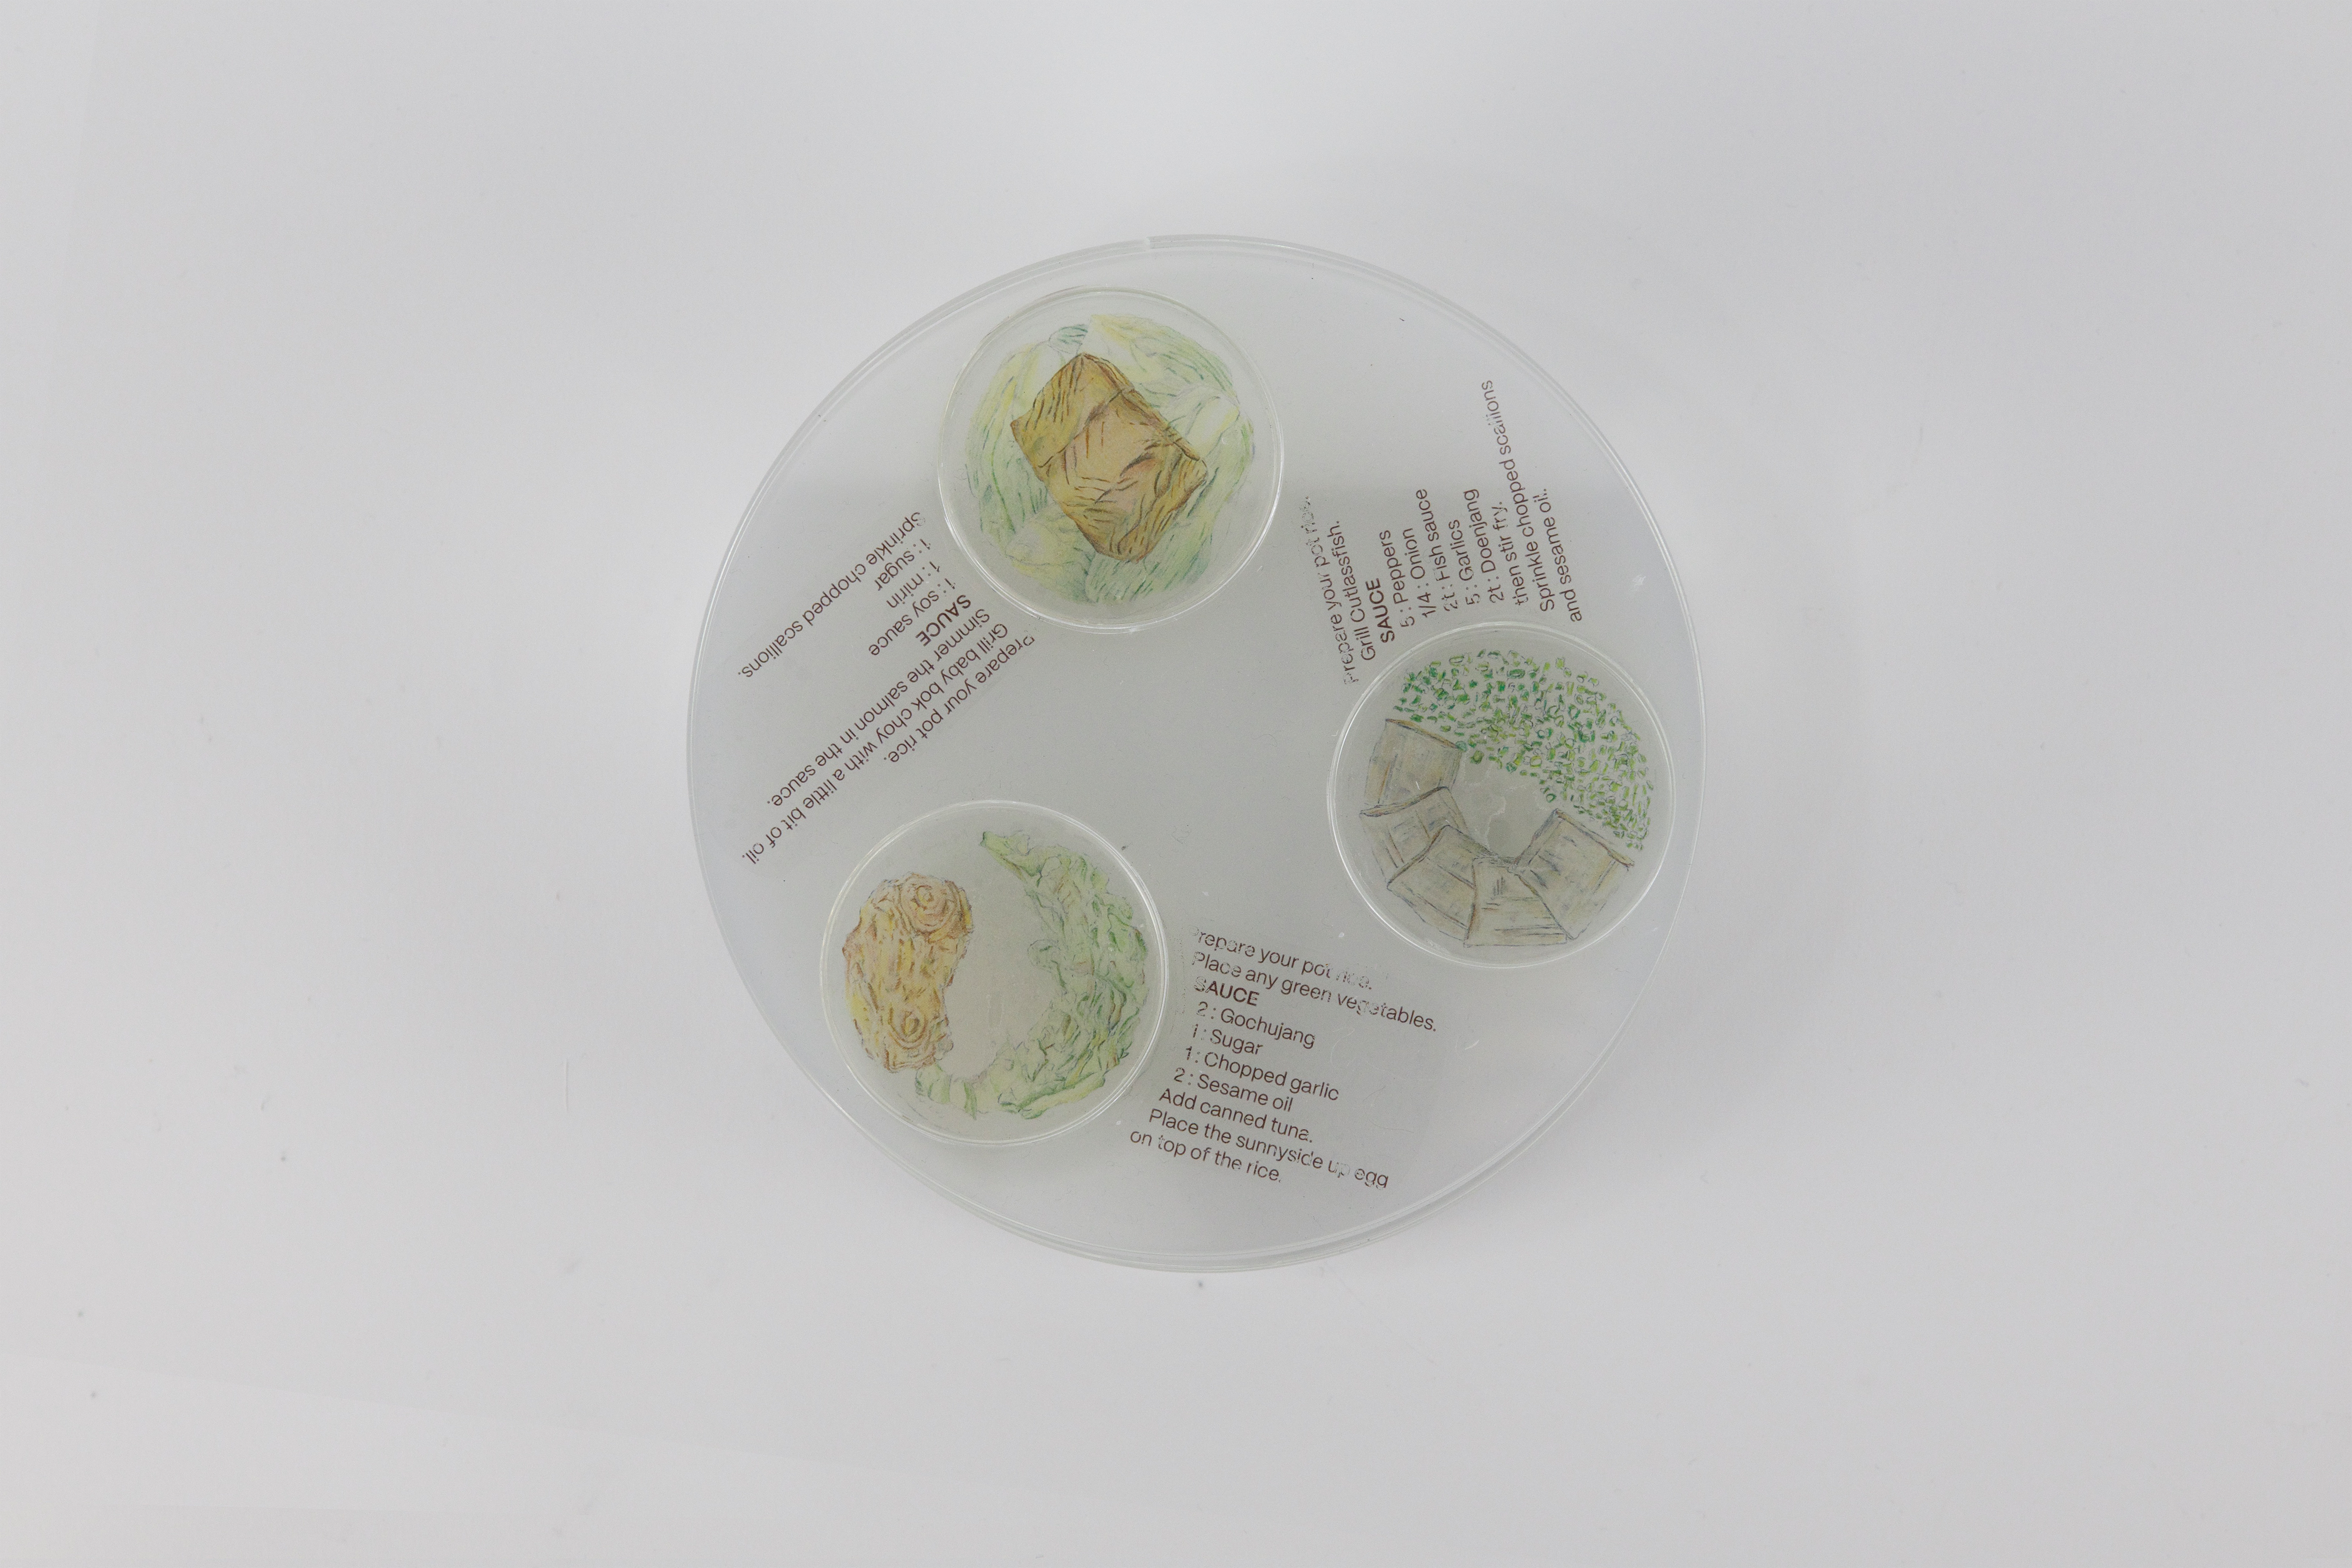

Sotbab
Poster Design
Programs:
Programs:
Illustrator, After Effects
Description
During my years studying abroad, I struggled to find nutritious recipes that suited my cooking skills. However, I discovered how to make Sotbab, a Korean dish known as hot stone pot rice. This dish became my healthy alternative to snacks and instant noodles, as it's simple to prepare and packed with nutrition. Once I mastered the basic recipe, I experimented with various ingredients such as beef, pork, abalone, mushrooms, and more, making it my favorite dish.
During my years studying abroad, I struggled to find nutritious recipes that suited my cooking skills. However, I discovered how to make Sotbab, a Korean dish known as hot stone pot rice. This dish became my healthy alternative to snacks and instant noodles, as it's simple to prepare and packed with nutrition. Once I mastered the basic recipe, I experimented with various ingredients such as beef, pork, abalone, mushrooms, and more, making it my favorite dish.
Inspired by my experience, I created this project to help fellow study-abroad students discover how to prepare Sotbab and maintain a balanced diet during their time away from home. I shared my recipe and highlighted readily available ingredients in the U.S., ensuring accessibility for students. To further connect with the theme, I used an acrylic panel to create a recipe pot, mimicking the appearance of a hot stone pot and layers of ingredients, making the presentation visually engaging.
This recipe is only my suggestion, but the ingredients can be modified in any way, which is the reason I made the ingredient circles easy to replace.
Layers

Process


